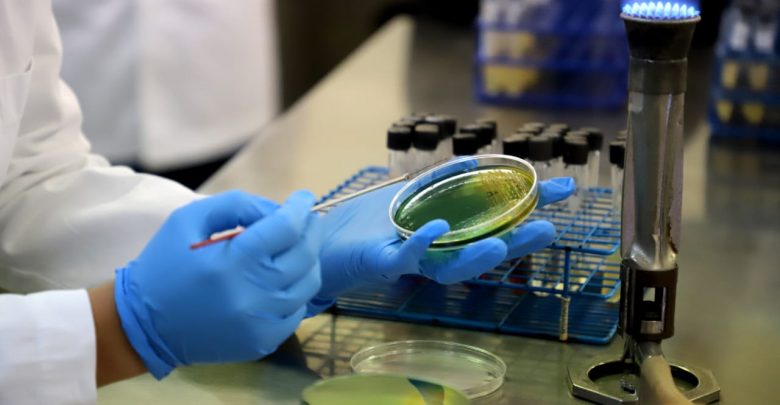

STAFF/@michangoonga
Ante la alerta internacional por nuevo Coronavirus (2019-nCoV), emitida por la Organización Mundial de la Salud (OMS), el Comité Estatal de Seguridad en Salud, reitera que la vigilancia epidemiológica en terminales marítimas y aeroportuarias de Michoacán, es permanente en las ocho jurisdicciones sanitarias de la entidad.
Lo anterior, a fin de identificar posibles casos de infección respiratoria asociados a este padecimiento, en los filtros sanitarios instalados; asimismo, se fortalecieron los protocolos de búsqueda intencionada de enfermedades respiratorias graves asociadas a este u otro virus en los hospitales.
Conformado por la Secretaría de Salud de Michoacán (SSM), el Instituto Mexicano del Seguro Social (IMSS), el Instituto de Seguridad y Servicios Sociales de los Trabajadores del Estado (ISSSTE), así como la Secretaría de la Defensa Nacional (Sedena), el comité hace un llamado a la población a no caer en pánico y no compartir información que no haya sido emitida por las autoridades correspondientes y canales oficiales de comunicación; al mismo tiempo que reiteró el exhorto a tomar todas las medidas preventivas que a continuación se enlistan.
- Lavado de manos frecuente usando agua y jabón
- Consumir sólo alimentos bien cocinados
- Beber agua simple potable o embotellada
- Evitar lugares concurridos
- No consumir carne cruda
- Evitar el contacto con personas enfermas
En caso de que una persona de cualquier edad presente fiebre, enfermedad respiratoria aguda y que cuente con antecedente de viaje o estancia en la ciudad de Wuhan provincia de Hubei, China, o haber estado en contacto con un caso confirmado o un caso bajo investigación hasta 14 días antes del inicio de síntomas, debe acudir a su unidad de salud más cercana para ser revisado por un especialista.
El Instituto de Diagnóstico y Referencia Epidemiológicos (InDRE), cuenta con los procedimientos e insumos necesarios para confirmar la presencia del virus 2019-nCoV en las muestras biológicas de los casos sospechosos.

